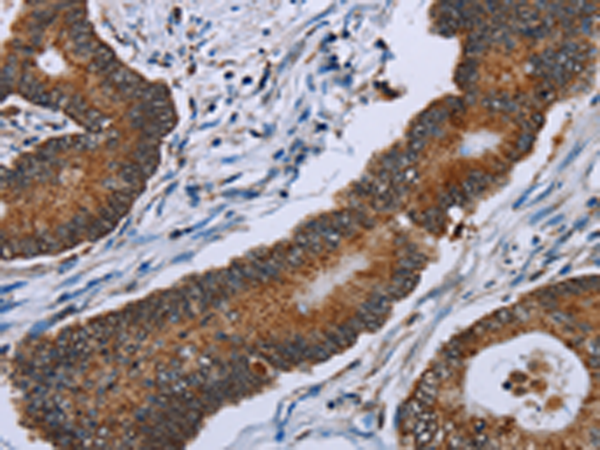
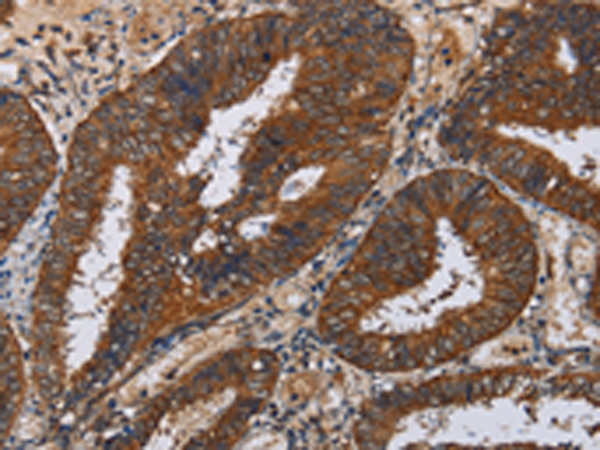

-
分类: 科研抗体货号: P08443别名:应用: IHC反应种属: Human, Mouse, Rat
-
分类: 科研抗体货号: P08427别名: IDH; IDP; IDHM; IDPM; ICD-M; D2HGA2; mNADP-IDH应用: WB,IHC反应种属: Human, Mouse, Rat
-
分类: 科研抗体货号: P08468别名: NP; HNP; NRPN; PRSS19; TADG14应用: IHC反应种属: Human
-
分类: 科研抗体货号: P08442别名: Imp4应用: WB,IHC反应种属: Human, Mouse
-
分类: 科研抗体货号: P08426别名: LW; CD242应用: WB,IHC反应种属: Human
-
分类: 科研抗体货号: P08467别名: TLSP; PRSS20应用: IHC反应种属: Human
-
分类: 科研抗体货号: P08441别名: LGL2; IMP13; KAP13; RANBP13应用: IHC反应种属: Human, Mouse, Rat
-
分类: 科研抗体货号: P08424别名: PIR2; IBRDC2; p53RFP; bA528A10.3应用: WB,IHC反应种属: Human, Mouse
-
分类: 科研抗体货号: P08463别名: MKLP2; RAB6KIFL应用: WB,IHC反应种属: Human, Mouse
-
分类: 科研抗体货号: P08440别名: CRL; GPL; CRL3; GLMR; GLM-R; PLCA2; hGLM-R; IL-31RA; PRO21384应用: WB,IHC反应种属: Human

鄂公网安备42018502007531号
鄂公网安备42018502007531号

